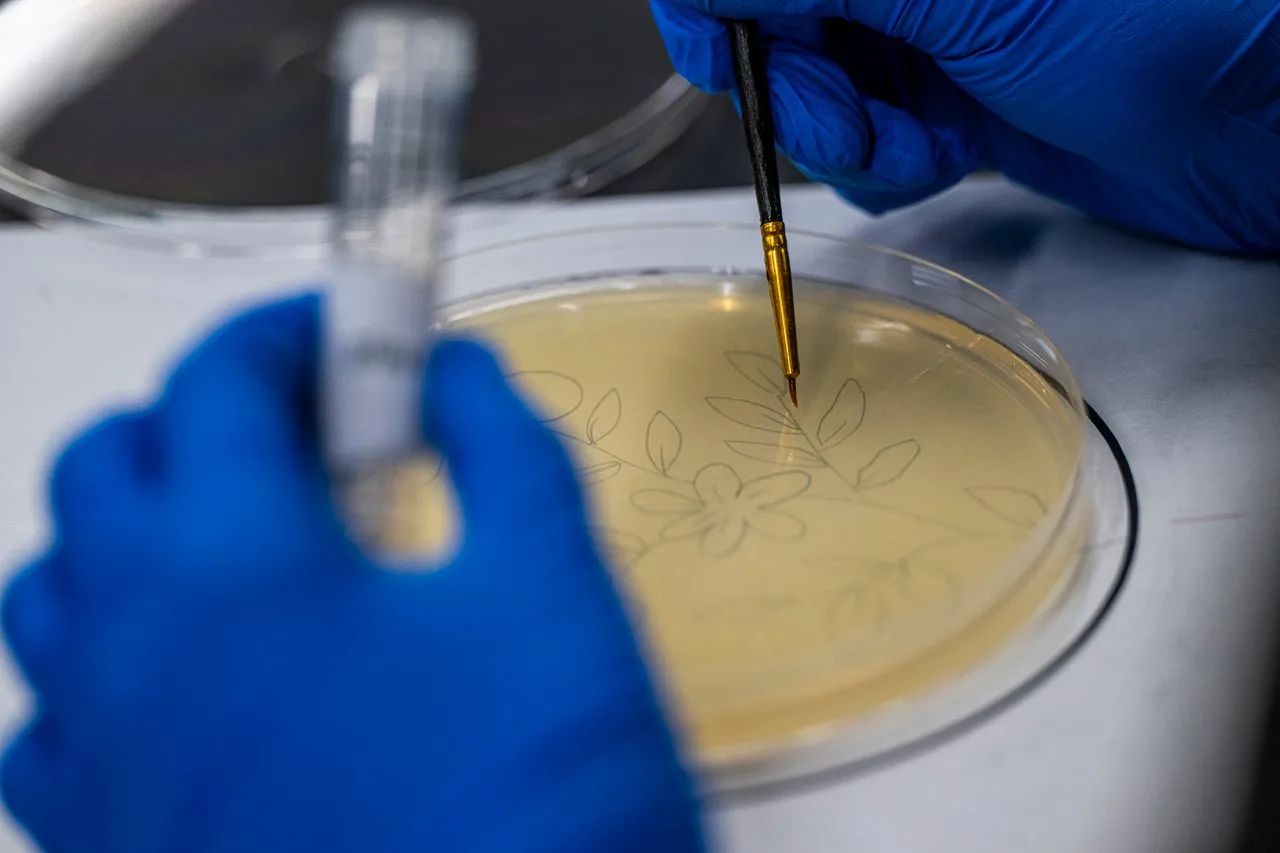

微觀世界:創作細菌畫,一門優雅而危險的藝術

2024年2月初的一個清晨,在密蘇里科技大學,戴維·韋斯滕伯格戴上護目鏡和乳膠手套。這位戴著眼鏡的微生物學家、27年來一直擔任生物科學教授的男人,小心翼翼地從一臺溫度設定在零下112華氏度(約零下80攝氏度)的冷柜中取出一系列裝有大腸桿菌菌株的試管。
這些大腸桿菌樣本已被植入了能夠產生色素的基因。然而,韋斯滕伯格即將培養的這種擁有2500萬至4000萬年演化史的微生物,并非出于常規的科研目的。
他手持木棒,小心翼翼地將這些菌株涂抹在已滅菌的培養皿上。皿中盛有富含營養的抗生素粉末和一層凝固的膠狀物質——瓊脂。這種肥沃的培養基將使細菌在未來幾天內生長并產生色素。待菌落形成后,他會將各菌株懸浮于生理鹽水中進行滅菌處理。唯有完成這些步驟,這些微生物才能供學生們用于情人節主題的瓊脂藝術創作——這項以細菌為顏料、培養皿為畫布的活體繪畫藝術,也被稱為微生物藝術(microbial art)。
要理解瓊脂藝術,必先認識瓊脂本身。這種從紅藻中提取的白色凝膠狀物質可用于烹飪(尤其制作甜點),更因其增稠穩定特性備受微生物學家青睞——當與營養物質結合時,它能形成固態培養基底,成為細菌生長與研究的舞臺。瓊脂藝術正是利用這種膠質培養基培養有色微生物,并通過畫筆的勾勒將其塑造成精妙圖案,讓科學與藝術在培養皿中翩然共舞。
然而,若操作不當,這門藝術背后暗藏危機——從微生物污染到病原體公眾傳播,皆可能釀成嚴重后果。
對畫筆進行嚴格滅菌并銷毀活體菌畫作品,能有效防范微生物向公眾傳播的風險。 微生物藝術的歷史可追溯至近百年前。這項藝術的創始人正是蘇格蘭醫師兼微生物學家亞歷山大·弗萊明——他因1928年發現世界上第一種抗生素(即眾所周知的青霉素)而聞名于世。據倫敦亞歷山大·弗萊明實驗室博物館館長凱文·布朗透露,這位"業余畫家"在做出改變世界的發現前,就一直在創作"細菌畫"。雖然已無從考證弗萊明具體何時及如何開始用細菌作畫,但他的活體畫作題材豐富:既有建筑素描、哺乳的母親,也有拳擊比賽中的噬菌體。 亞歷山大·弗萊明(Alexander Fleming)不僅發明了青霉素,還開創了細菌藝術這一獨特領域。 頗具諷刺的是,盡管弗萊明被公認為微生物藝術的開山鼻祖,但這位微生物學家與其同時代人卻從未將這些創作視作正經藝術。"這些作品只是他的消遣,用來逗樂家人朋友,從未公開展示,"布朗解釋道,"當時根本無人知曉這些存在——它們更像是實驗室里的奇趣玩意,而非真正的藝術品。" 這些"實驗室奇趣"在公眾視野邊緣徘徊了近一個世紀,直到2015年美國微生物學會ASM創辦年度瓊脂藝術大賽,才將這種科學藝術形式推向國際舞臺。對許多微生物學家而言,正是這項賽事讓他們首次接觸瓊脂藝術。 印度班加羅爾研究院生物科學系助理教授巴拉拉姆·卡馬里2019年經同事推薦得知ASM大賽后開始了創作。"用枯燥日常培養的細菌創造有趣作品,這種體驗簡直超現實,"這位自幼習藝的科學家說,2020年他以象征祖國的《微生物孔雀》獲ASM傳統組亞軍,此后持續精進這項技藝。 如今的瓊脂藝術已發展得極為精妙絕倫,以巴拉拉姆·卡馬里(Balaram Khamari)的獲獎作品為例。 韋斯滕伯格的瓊脂藝術創作始于十五年前。當時,他利用一種名為發光桿菌的生物熒光細菌,為參加夏令營的女兒制作了會發光的培養皿生日賀卡和小夜燈。"這就是微生物學家子女的'特殊待遇',"他開玩笑說道。如今,他主要使用大腸桿菌進行創作,全年為學生舉辦各類瓊脂藝術活動,并面向公眾開展科普推廣,旨在激發各年齡段、各學科背景人群的科學興趣。 不過,韋斯滕伯格必須采取嚴格的安全防護措施,以防止有害細菌的潛在傳播。在活動當天,他會對細尖畫筆和彩色菌株進行消毒處理。隨后,他將11種不同顏色的菌株分裝至無菌塑料試管中,供學生們作畫使用。 學生們首先在白紙上勾勒圖案輪廓,隨后將無菌培養皿覆蓋其上,用特制畫筆蘸取菌液進行臨摹。此時的創作宛若隱形墨水——唯有當完成的作品被倒置于恒溫37℃(98.6華氏度)的培養箱中24至48小時后,繽紛的菌落色彩才會逐漸顯影綻放。 在韋斯滕伯格的課堂上,所有藝術成品都會經過高溫蒸汽滅菌處理,以確保細菌被徹底滅活。 成熟的菌畫作品能保持鮮艷色澤長達數月,待其自然褪色后,將統一經高壓蒸汽滅菌器進行無害化處理。 盡管韋斯滕伯格是科班出身的專業人士,但近年來業余微生物愛好者也紛紛涉足這門藝術。對此,學界態度呈現明顯分歧:一方面,這種趨勢總體獲得認可與鼓勵;另一方面,以布朗為代表的專家則持審慎態度。 細菌操作始終存在固有風險,因此安全防護是韋斯滕伯格教學活動的重中之重。在他的課堂上,佩戴乳膠手套、護目鏡以及勤洗手都是強制要求。工作臺旁常備裝有漂白劑的噴霧瓶和紙巾,以應對可能的濺灑事故。而且他只使用被列為一級風險的非致病性大腸桿菌等安全菌株。韋斯滕伯格特別指出,即便是公認最無害的菌株,在特定條件下仍可能造成危害。 然而,這些潛在風險并未減弱他對瓊脂藝術的推崇。在他看來,這項藝術最珍貴的價值在于喚醒人們對微生物世界之美與多樣性的認知。 從某種意義上說,瓊脂藝術的流行延續了微生物學家們長久以來的努力——扭轉自人類發現細菌以來就存在的污名化認知。對韋斯滕伯格而言,這更是一個絕佳的科普契機:讓不同背景、年齡的人們通過藝術創作,學會以謹慎而敬畏的態度對待這些自生命起源之初就塑造著、并將繼續塑造我們世界的微觀生命。 "細菌是亙古存在的生命始祖,"韋斯滕伯格的指尖輕撫過培養皿的邊緣,菌落在實驗室的燈光下泛著虹彩,"三十五億年的進化史詩,讓它們征服了這顆星球的每個維度——從分解污染物到固氮成壤,如今我們更發現其與人體免疫、消化系統存在著精妙的共生關系。" 他關閉培養箱時,不銹鋼門映出他若有所思的面容:"恐懼源于無知,而科學賦予我們理性尊重的力量。這些看似微末的生命體,實則是維系地球生命網絡的隱形工程師。"

